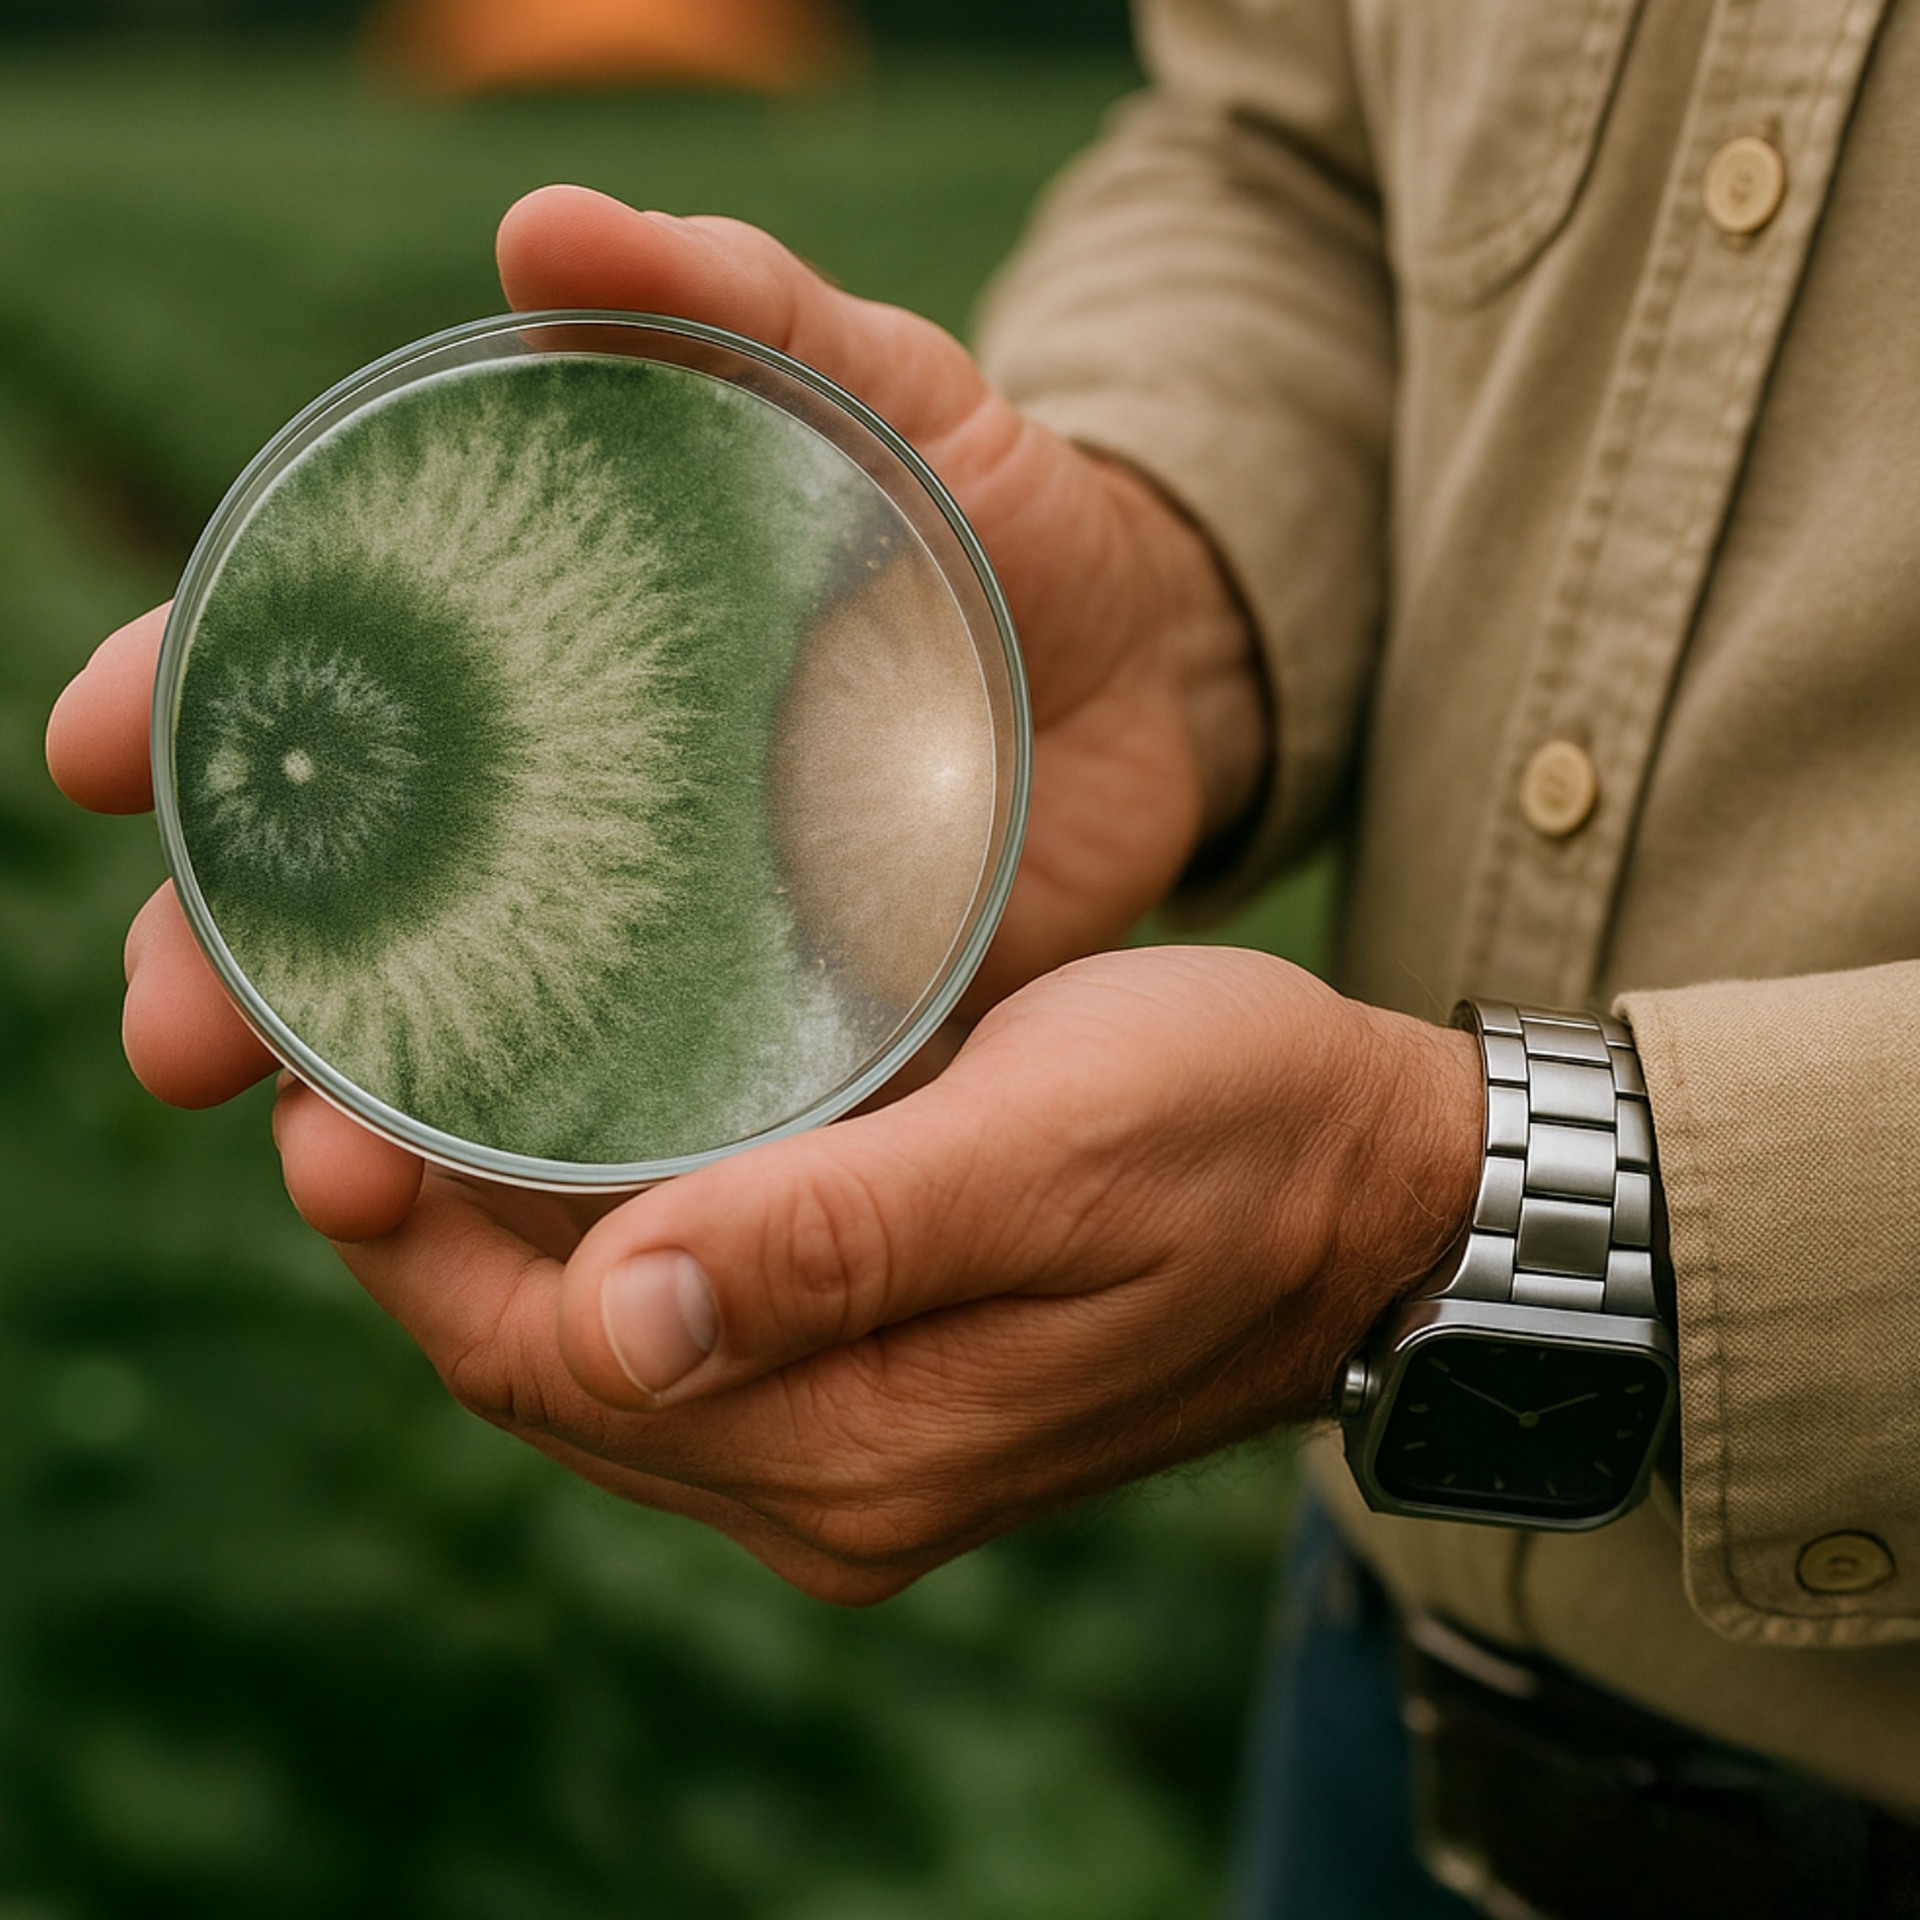

Nema Blinder
- Trichoderma harzianum ESALQ 1306
- Hongos beneficiosos
-
Aumenta la absorción de nutrientes.
-
Restaura el equilibrio nutricional de las plantas.
-
Estimula el crecimiento radicular y la vitalidad de las plantas.
- Saltar a:
- Utilizar para
Utilizar para
Utilizar para
Nema Blinder es un producto versátil que puede ser aplicado en todos los cultivos, permitiendo un mejor desarrollo de la planta, manteniendo la actividad en la rizósfera. Ventajas:
- Mejora el vigor y el desarrollo de las raíces.
- Protege la raíz de patógenos de suelo.
- Mayor actividad en la rizósfera de la planta.
Se aplican las condiciones generales de Koppert (Koppert B.V. y/o sus empresas afiliadas). Solo se deben usar productos autorizados en su país o estado y cultivo. Cumpla en todo momento con la obligación de registro local. Koppert no se responsabiliza del uso no autorizado del producto. Koppert no se responsabiliza de la pérdida de calidad, si el producto se almacena durante más tiempo del recomendado o bajo condiciones no apropiadas.